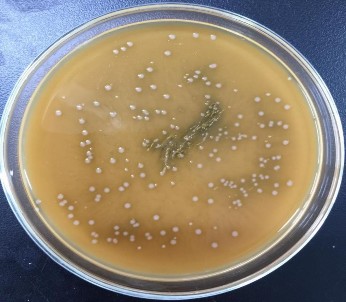
Hình 3 2 Đặc điểm khuân lạc chủng vi khuẩn L6 Như vậy qua quan sát đặc 2

CHƯƠNG 3. KẾT QUẢ VÀ THẢO LUẬN
3.1. Phân lập và định danh chủng vi khuẩnLactobacillus
Để nghiên cứu ảnh hưởng của các điều kiện stress môi trường lên quá trình sinh tổng hợp EPS ở L. plantarum, nghiên cứu đã phân lập các chủng Lactobacillus từ thực phẩm lên men tại An Giang (Việt Nam) và chọn lọc ban đầu bằng các xét nghiệm sinh hóa, sau đó kiểm tra khả năng sinh tổng hợp EPS. Từ 6 mẫu thực phẩm lên men, nghiên cứu đã phân lập được 19 chủng vi khuẩn có đặc điểm điển hình của LAB. Đặc điểm hình thái, sinh hoá của các chủng phân lập được mô tả ở bảng 3.1, hình 3.1 và 3.2.
Bảng 3.1. Đặc điểm hình thái, sinh hóa của các chủng LAB được phân lập từ thực phẩm lên men
Gram | Hình dạng tế bào | Thử nghiệm catalase | |
CK1, CK3, CK4, CK5, L1, L2, L3, L5, L6, DC2, RM, RM1, CC1, CC2 | + | Que ngắn | - |
CK6, CK7, L4, DC1 | + | Que dài | - |
N1 | + | Cầu | - |
Có thể bạn quan tâm!
-
Sơ Đồ Tổ Chức Di Truyền Của Cụm Gen Eps Trong L. Plantarum. Pb: Sinh Tổng Hợp Tiền Chất, Of: Chức Năng Khác Liên Quan Đến Eps, Dec: Nhóm Khác, Otr: Điều -
Stress Môi Trường Và Đáp Ứng Sinh Tổng Hợp Eps Ở Lab -
Các Phương Pháp Phân Lập Và Tuyển Chọn Vi Khuẩn L. Platarum -
Sự Thay Đổi Mật Số L. Plantarum Val6 Dưới Điều Kiện Stress Ph Cùng Với Kiểm Tra Mật Số, Sự Sống Sót Sau Sấy Đông Khô Của L. Plantarum -
Mật Số Vi Khuẩn Probiotic Được Nuôi Cấy Trong Môi Trường Mrs Không Đường Có Bổ Sung Eps Của L. Plantarum Val6 -
Tỷ Lệ Các Monosaccharide: (A) Mannose; (B) Glucose; (C) Galactose; (D) Arabinose; (E) Rhamnose Và (F) Xylose Trong Eps Được Sản Xuất Bởi L. Plantarum Val6 Dưới Điều
Xem toàn bộ 169 trang tài liệu này.
Kết quả bảng 3.1 cho thấy các chủng LAB phân lập được đều có Gram dương do bắt màu xanh tím của thuốc nhuộm crystal violet. Kết quả thử nghiệm catalase đều âm tính. Quan sát khuẩn lạc sau 36 giờ nuôi cấy trên môi trường MRS nhận thấy các khuẩn lạc đều có màu trắng sữa hoặc trắng ngà, tròn, bóng, lồi, bìa nguyên. Về hình thái, hầu hết tế bào của các chủng phân lập đều có hình que thẳng hoặc cong, dài hoặc ngắn, ngoại trừ chủng N1.

Hình 3.1. Hình dạng tế bào chủng vi khuẩn L6 dưới kính hiển vi quang học
Hình 3.2. Đặc điểm khuân lạc chủng vi khuẩn L6
Như vậy, qua quan sát đặc điểm hình thái cho thấy phần lớn các chủng LAB thuộc nhóm Lactobacillus sp. Ngoài ra, các chủng phân lập đều có đặc điểm điển hình của LAB như được mô tả bởi các nghiên cứu trước đây [187,188]. Marroki và cs. (2011) khi phân lập LAB trên sữa dê cũng có các đặc điểm hình thái tương tự [189].
7
Hàm lượng EPS (g/L)
6
5
4
3
2
1
0
![]()
![]()
![]()
![]()
![]()
![]()
![]()
Chủng vi khuẩn
Hình 3.3. Khả năng sản xuất EPS của các chủng LAB phân lập từ thực phẩm lên men
Để lựa chọn chủng LAB sản xuất EPS cao, nghiên cứu đã đánh giá khả năng sản xuất EPS của các chủng phân lập trong môi trường MRS. Kết quả cho thấy trong cùng một điều kiện nuôi cấy, hầu hết các chủng phân lập đều có khả năng sản xuất EPS nhưng với các mức độ khác nhau. Năng xuất EPS dao động trong khoảng từ 3,4 đến 5,7 g/L (Hình 3.3). Trong số các chủng vi khuẩn này, chủng L6 có khả năng sản xuất EPS cao nhất đạt 5,72 g/L và khác biệt có ý nghĩa thống kê so với các chủng còn lại (Bảng 1.1 phụ lục trang 126).
Hình 3.4. Kết quả BLAST SEARCH để phân loài chủng L6
Tổng hợp EPS là một quá trình phức tạp trải qua nhiều phản ứng sinh hoá phức tạp dưới sự xúc tác của các enzyme chuyên biệt. Năng xuất EPS được sản xuất bởi LAB thường không giống nhau, tùy thuộc vào loài, nguồn dinh dưỡng và điều kiện nuôi cấy cụ thể [48]. Trong nghiên cứu này, các chủng LAB phân lập đều có khả năng sản xuất EPS với những mức độ khác nhau mặc dù được nuôi cấy trong cùng một điều kiện. Điều này có thể là do sự khác nhau về số lượng và mức độ hoạt động của các enzyme liên quan trong quá trình sinh tổng hợp EPS như glucosyltranpherase, hoặc là fructosyltranpherase (trong quá trình sinh tổng hợp HoPS) hay phosphoglucomutase, glycosyltransferase và flippase (trong quá trình sinh tổng hợp HePS).
Với khả năng sản xuất EPS cao nhất, chủng L6 được định danh bằng phương pháp giải trình tự gen 16S rRNA với cặp mồi 1492R và 27F. Kết quả so sánh trình tự tương đồng bằng công cụ Nucleotide BLAST tại http://www.ncbi.nlm.nih.gov/ cho thấy chủng phân lập L6 tương đồng 99,33% với L. plantarum strain L2 và L. plantarum strain MG26 (Hình 3.4 và 3.5).

Hình 3.5. Cây phát sinh loài của chủng L. plantarum VAL6 được xây dựng bằng cách so sánh trình tự 16S rRNA
Để đảm bảo chính xác chủng L6 là L. plantarum, nghiên cứu đã kiểm tra kích thước sản phẩm khuếch đại PCR của gen recA. Kết quả cho thấy kích thước sản phẩm khuếch đại là 318 bp (Hình 3.6), phù hợp với gen recA của L. plantarum [181]. Do đó chủng L6 được đặt tên là L. plantarum VAL6.
318 bp
Hình 3.6. Sản phẩm khuyếch đại PCR của gen recA. Giếng 1: DNA ladder, Giếng 2: Đối chứng âm, Giếng 3-5: Sản phẩm khuếch đại PCR gen recA
Như vậy nghiên cứu đã phân lập thành công chủng L. plantarum VAL6 có khả năng sản xuất EPS cao. Do đó, chủng này được sử dụng cho nghiên cứu xa hơn về ảnh hưởng của stress môi trường lên quá trình sinh tổng hợp EPS.
3.2. Ảnh hưởng của stress môi trường lên khả năng sinh tổng hợp EPS ở L. plantarum VAL6
3.2.1. Stress nhiệt
Với vai trò bảo vệ vi khuẩn khỏi các điều kiện môi trường bất lợi, việc sản xuất EPS được kích thích bởi các stress môi trường khác nhau [139-141]. Để chứng minh liệu giả thuyết này có đúng khi L. plantarum được tiếp xúc với nhiệt độ cao. Nghiên cứu đã thực hiện gây stress L. plantarum VAL6 ở các điều kiện nhiệt độ 42 và 47 oC, sau đó phân tích hàm lượng EPS tạo thành, khả năng sống sót của vi khuẩn trong suốt thời gian gây stress và sau khi sấy đông khô. Kết quả nghiên cứu cho thấy các điều kiện stress nhiệt làm tăng đáng kể hàm lượng EPS được sản xuất bởi L. plantarum VAL6 từ 1 giờ sau khi xử lý và giữ ổn định ở mức cao so với điều kiện nuôi cấy bình thường cho đến khi kết thúc thời gian gây stress được kiểm tra (7 giờ) (Hình 3.7).
![]()
![]()
42°C 47°C Không stress
*
Hàm lượng EPS (g/L)
14
13
12
11
10
9
8
7
0 1 2 3 4 5 6 7
Thời gian (giờ)
Hình 3.7. Năng suất EPS được sản xuất bởi L. plantarum VAL6 dưới điều kiện stress nhiệt. Dấu sao (*) biểu thị sự khác biệt có y nghĩa (p<0,05) về hàm lượng EPS giữa các xử lý 42 và 47 °C ở cùng thời gian
Sau 3 giờ gây stress, năng suất EPS đạt tối đa là 13,27 và 13,48 g/L tương ứng với xử lý ở nhiệt độ 42 và 47 oC. Kết quả này cao hơn 1,5 lần so với đối chứng không gây stress (chỉ khoảng 8 g/L). Khi so sánh giữa hai nhiệt độ xử lý 42 và 47
°C, năng suất EPS trung bình cao hơn khi L. plantarum VAL6 được gây stress ở 47
°C nhưng khác biệt này không có ý nghĩa thống kê (p > 0,05) (Bảng 2.1.1 phụ lục trang 126). Tuy nhiên, năng suất EPS sau 7 giờ xử lý ở 47 °C thấp hơn so với 42 °C (Hình 3.7). Có thể nhiệt độ cao trong thời gian dài làm chết vi khuẩn và EPS bị thủy phân. Những kết quả này chứng minh stress nhiệt độ cao có thể kích thích L. plantarum VAL6 sản xuất EPS nhiều hơn.
Các điều kiện stress môi trường được chứng minh ảnh hưởng đáng kể đến sự sống sót, sự tăng trưởng, khả năng lên men và khả năng tồn tại của tế bào [190]. Để xác định khả năng chịu đựng stress nhiệt của L. plantarum VAL6, nghiên cứu đã phân tích sự thay đổi mật số vi khuẩn theo thời gian stress nhiệt. Nhìn chung, mật số L. plantarum VAL6 thay đổi không đáng kể trong suốt thời gian gây stress (Hình 3.8). Ở điều kiện stress 42 oC, mật số L. plantarum VAL6 khác biệt không có ý nghĩa (p> 0,05) khi so sánh với đối chứng không gây stress (Bảng 2.1.3 phụ lục trang 126). Tuy nhiên, ở điều kiện stress 47 oC, mật số L. plantarum VAL6 giảm sau 5 giờ gây stress và khác biệt có ý nghĩa so với 42 oC (Hình 3.8). Điều này có thể được giải thích là việc xử lý ở nhiệt độ cao trong thời gian dài làm vi khuẩn bị chết.
Mật số (Log CFU/mL)
9,5
9
8,5
8
7,5
7
Không stress 42 ˚C 47 ˚C
*
*
![]()
![]()
0 1 2 3 4 5 6 7
Thời gian (giờ)
Hình 3.8. Sự thay đổi mật số L. plantarum VAL6 dưới điều kiện stress nhiệt. Dấu sao (*) biểu thị sự khác biệt có y nghĩa (p<0,05) về mật số vi khuẩn giữa các xử lý 42 và 47 °C ở cùng thời gian
Một số nghiên cứu đã chứng minh vi khuẩn sản xuất nhiều EPS hơn thì có khả năng sống sót cao hơn trong các điều kiện môi trường khắc nghiệt [191]. Do đó nghiên cứu đã kiểm tra khả năng sống sót sau sấy đông khô của L. plantarum VAL6 sau khi được stress nhiệt. Kết quả cho thấy tỷ lệ sống sót sau đông khô của vi khuẩn được gây stress cao hơn đáng kể so với vi khuẩn không được gây stress (Hình 3.9).
![]()
![]()
Không stress 42 ˚C 47 ˚C
Tỷ lệ sống sót (%)
12
10
8
6
4
2
0
0 1 2 3 4 5 6 7
Thời gian (giờ)
Hình 3.9. Tỷ lệ sống sót sau đông khô của L. plantarum VAL6 được stress nhiệt Tỷ lệ sống sót sau đông khô của L. plantarum VAL6 được gây stress ở 42 oC
từ 3 – 7 giờ dao động khoảng 6%, trong khi tỷ lệ này ở 47 oC là 10%. Từ kết quả này cho thấy nhiệt độ gây stress càng cao thì tỷ lệ sống sót sau sấy đông khô của L. plantarum VAL6 càng tăng. Trong khi đó, tỷ lệ sống sót sau đông khô của vi khuẩn không được gây stress là rất thấp và ít thay đổi trong suốt thời gian stress được kiểm tra.
Qua các kết quả có được, có thể thấy khả năng sản xuất EPS ở L. plantarum VAL6 được cải thiện dưới điều kiện stress nhiệt. Kết quả này có thể được giải thích là do vi khuẩn tổng hợp nhiều EPS hơn như một đáp ứng với stress nhiệt. Các EPS này đóng vai trò như một rào cản ngăn cách giữa tế bào với môi trường bất lợi [2,192] và bảo vệ tế bào khỏi các tác động tiêu cực của nhiệt độ cao [140]. Garibay và Marshall (1991) cũng đã chứng minh năng suất EPS do L. delbrueckii ssp. bulgaricus sản xuất ở 48 °C gấp đôi so với ở nhiệt độ tối ưu (37 - 42 °C) [193].
Ngoài ra, sự tăng cường sản xuất EPS dưới tác động của nhiệt độ cao có thể giúp cải thiện khả năng sống sót của vi khuẩn. Do đó vi khuẩn được stress nhiệt có tỷ lệ sống sót sau sấy đông khô cao hơn đáng kể so với vi khuẩn không được gây stress. Để hỗ trợ cho nghiên này, một nghiên cứu khác cũng đã chứng minh stress nhiệt dưới ngưỡng gây chết thúc đẩy quá trình tổng hợp EPS và tăng khả năng sống sót sau sấy đông khô của B. bifidum [162].
3.2.2. Stress pH
Nhiều nghiên cứu đã chứng minh có mối tương quan giữa sản xuất EPS ở LAB và pH môi trường thay đổi [142,143]. Trong nghiên cứu này, để kiểm tra mối
tương quan giữa stress pH và sản xuất EPS, L. plantarum VAL6 được tiếp xúc với các điều kiện stress pH 3 và 8. Kết quả cho thấy stress pH tăng cường mạnh mẽ khả năng sinh tổng hợp EPS ở L. plantarum VAL6 (Hình 3.10).
Không stress
pH 3
pH 8
Hàm lượng EPS (g/L)
60
50
40
30
20
10
0
0 1 2 3 4 5 6 7
Thời gian (giờ)
Hình 3.10. Năng suất EPS được sản xuất bởi L. plantarum VAL6 dưới điều kiện stress pH
Theo đồ thị hình 3.10, năng suất EPS được sản xuất bởi L. plantarum VAL6 dưới điều kiện stress ở pH 3 cao hơn so với điều kiện stress ở pH 8 và không gây stress. Sau 3 giờ stress ở pH 3, năng suất EPS đạt cao nhất (hơn 50 g/L) và cao hơn 6,4 lần so với đối chứng không gây stress (chỉ khoảng 7,8 g/L). Trong khi dưới điều kiện stress pH 8 ở cùng thời gian, năng suất EPS đạt khoảng 16 g/L và cao hơn 2,1 lần so với đối chứng. Các kết quả này cho thấy L. plantarum VAL6 tăng cường mạnh mẽ sự tổng hợp EPS dưới các điều kiện stress pH cao và thấp.
Song song với xác định hàm lượng EPS, mật số của L. plantarum VAL6 dưới các điều kiện stress pH đã được kiểm tra (Hình 3.11). Ở điều kiện stress pH 8, kết quả phân tích cho thấy sau 5 giờ đầu của quá trình gây stress, mật số L. plantarum VAL6 gần như không thay đổi so với đối chứng. Nhưng sau 7 giờ gây stress, mật số vi khuẩn giảm nhẹ. Tuy nhiên, ở điều kiện stress pH 3, mật số của L. plantarum VAL6 giảm mạnh theo thời gian xử lý. Sau 7 giờ gây stress ở pH 3, mật số L. plantarum VAL6 còn lại 5,25 Log CFU/mL, giảm khoảng 43% so với ban đầu.






